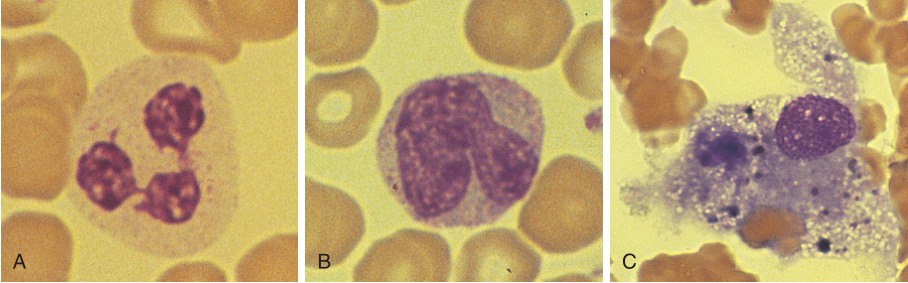

导 读
本章讨论先天免疫系统的另一个组成部分,吞噬细胞,本章将详细阐述中性粒细胞和巨噬细胞这两种吞噬细胞之间的区别,以及它们如何识别和杀死病原体。
吞噬作用是指细胞将颗粒物内化为细胞质小泡,通常在吞噬细胞识别到病原体时被触发。吞噬细胞中含有溶酶体,它是一种含有酶的颗粒,这些酶能与小泡融合并降解颗粒物。此外,一系列吞噬细胞酶的激活会导致有毒分子的产生,即氧化爆发,这是杀死和吞噬病原体的必要条件。因此,吞噬细胞主要负责清除微小的细胞外病原体,如细菌、原生动物、真菌和细胞碎片等。吞噬细胞第二个重要作用是可以产生细胞因子和细胞表面分子向适应性免疫系统传递感染的信号。
吞噬细胞的类型
吞噬细胞是骨髓源性(髓系)细胞。人类进化出了一系列吞噬细胞,每种细胞都有其特定的功能。
中性粒(白)细胞
中性粒细胞具有独特的、可辨认的形态(Fig.21.1)。血液中中性粒细胞的数量变化较大(见 Fig.21.1A)。人体处于稳态时,每天都会产生中性粒细胞,但存活时间不会超过几个小时。而被感染时,中性粒细胞产生的数量增加,在血液中的数量显著上升(见Box 20.1)。感染期间中性粒细胞会迅速迁移到感染部位杀死病原体。中性粒细胞成功杀死了病原体,但它们自己也无法存活。感染部位形成的脓液大部分是死亡的中性粒细胞。中性粒细胞在抵御细菌感染的早期防御中起着至关重要的作用。因此,中性粒细胞缺陷/水平低(减少症)的患者特别容易发生严重的细菌感染(见 Box 21.1)。
Fig 21.1 吞噬细胞。A、中性粒细胞B、单核细胞(未成熟的巨噬细胞)C,具有更独特外观的单核细胞
单核细胞/巨噬细胞
单核细胞(见Fig.21.1B)也是髓系细胞,但与中性粒细胞有很大不同 (Table 21.1)。血液中的单核细胞是未成熟的细胞,它们可以迁移到发挥活性的部位。单核细胞迁移到组织中成熟后分化为巨噬细胞(见Fig.21.1C),并产生多种特殊形式(Fig.21.2)。所有巨噬细胞形式都有很长的寿命,可在组织中存活数月或数年。

Table 21.1 中性粒细胞与巨噬细胞的比较

Fig 21.2 粒细胞集落刺激因子(G-CSF)在急性期反应中增加中性粒细胞的产生,巨噬细胞则少量产生,并在不同组织中发育成特化类型
组织巨噬细胞
组织巨噬细胞是一种具有特殊颗粒和胞质隔室的大细胞,广泛分布于各个部位。在某些组织中,如骨髓和淋巴结,这些活跃的巨噬细胞被称为histiocytes。
巨细胞和上皮样细胞
在慢性炎症部位,巨噬细胞在T细胞因子的影响下进一步成熟,成为多核巨细胞或上皮样细胞。上皮样细胞和巨细胞是肉芽肿形成的特征(第23章),它们通过向T细胞呈递抗原和分泌细胞因子延长炎症反应。与中性粒细胞不同,巨噬细胞可以存活很多年,并且在这种类型的炎症过程中不会形成脓液。
固定巨噬细胞
固定吞噬细胞主要存在与脾脏和肝脏的血窦。在肝脏中,这些巨噬细胞被称为Kupffer cells(库普弗细胞),作用是吞噬循环中的颗粒物,并在某些情况下可以吞噬整个细胞(见第29章中的溶血性贫血)。
肺泡巨噬细胞
肺泡巨噬细胞有助于肺的先天防御。它们参与慢性阻塞性肺疾病(COPD)等疾病过程。
胶质细胞
胶质细胞是驻留在神经系统中寿命较长的巨噬细胞,它们参与清除死亡神经细胞的过程。
破骨细胞
破骨细胞最特殊的巨噬细胞,它们通过骨吸收和向血液中释放钙来调节钙代谢。
吞噬细胞的产生
中性粒细胞和单核细胞是由骨髓中相同的干细胞产生的(见Fig.21.2和第12章)。每天产生的中性粒细胞比单核细胞多很多。这种机制特别容易受到细胞毒性药物的影响,导致中性粒细胞减少和人体易感(见Box21.1)。这些细胞的产生受集落刺激因子(CSFs)的调控,急性期反应时组织巨噬细胞会产生CSFs,确保在感染期间产生越来越多的中性粒细胞。重组粒细胞CSF可用于增加中性粒细胞数量,例如干细胞移植之后。
吞噬细胞的募集
单核细胞不断向健康组织迁移,并分化为前面所述的巨噬细胞。巨噬细胞通常处于静息状态,除非它们受到与其受体结合的信号的刺激。尽管血液中循环的吞噬细胞大部分是中性粒细胞,但它们在正常组织中是不存在的,只会迁移到炎症组织中(Fig.21.3)。中性粒细胞可被辅助性T细胞(TH17)分泌的白细胞介素17(IL-17)和巨噬细胞分泌的细胞因子及趋化因子募集到炎症部位。例如,局部巨噬细胞产生的细胞因子刺激局部毛细血管内皮细胞增加P-选择素和整合素(如细胞间黏附分子)的表达,然后以类似于第13章描述的募集淋巴细胞的方式募集中性粒细胞。

Fig 21.3 中性粒细胞的迁移
趋化因子是一种低分子量的趋化细胞因子,可引导细胞到特定位置,大约有十几种趋化因子和趋化因子受体存在。感染部位的巨噬细胞可以分泌IL-8等趋化因子。它们可修饰中性粒细胞表达的整合素使其黏附能力更强,从而与内皮细胞结合,并通过血细胞渗出穿过完整的血管壁进入组织(第13章)。趋化因子介导的最后一步是趋化,即细胞沿趋化因子梯度定向迁移。最终中性粒细胞被募集到组织中。有趣的是,募集中性粒细胞进入炎症组织的趋化因子会刺激局部树突状细胞离开淋巴结,从而激活适应性免疫系统。补体级联激活产生的过敏性毒素(第20章)对吞噬细胞也有一定的趋化作用。
综上所述,位于感染部位的常驻巨噬细胞分泌的细胞因子和趋化因子可刺激机体中性粒细胞产生增多,中性粒细胞和内皮细胞的选择素和整合素表达增多,从而促进中性粒细胞与局部血管内皮细胞的粘附,最终使中性粒细胞向感染部位发生趋化,感染部位的TH17细胞可通过分泌IL-17来实现这一作用。
吞噬细胞上的受体
细胞膜上的各种受体在吞噬细胞穿过组织以及与病原体或受损细胞的接触过程中发挥着重要作用(Fig.21.4)。
•趋化因子受体和细胞因子受体可将吞噬细胞募集到炎症部位。
•吞噬细胞使用至少两种不同类型的模式识别受体来识别病原体和损伤相关的分子模式。

Fig 21.4 吞噬细胞受体
分子模式
Toll样受体
Toll样受体(TLRs,第19章)是一个至少由10个不同的膜分子组成的家族,每一种膜分子都能识别不同类型的病原体分子,如Table21.2所示。不同的TLRs具有重叠作用,一种感染很可能会触发几种不同的受体。TLRs存在于巨噬细胞和其他抗原提呈细胞(APC)上,如树突状细胞和B细胞,也存在于其他细胞,如上皮细胞,这些细胞具有识别感染的作用。在与病原体分子结合时,TLRs启动细胞内信号,产生细胞因子。如本章末尾Box21.2所述,TLRs具有如此强大的作用,因此它们可能会作为药物靶标发挥重要作用。

Table 21.2 TLRs及其配体
C型凝集素受体
凝集素是糖结合蛋白,这些糖被C型凝集素受体识别为病原体细胞表面的糖脂(或糖蛋白)上的序列或濒临死亡的哺乳动物细胞上的序列。C型凝集素受体被结合后会激活巨噬细胞,并产生细胞因子,它们还能牢固地与病原体结合。通过这种方式,C型凝集素受体捕获病原体并将它们运送到内吞途径中。在专职APC如巨噬细胞和树突状细胞中,C型凝集素受体是降解病原体、随后呈递给T细胞所必需的。
补体成分受体
通过识别和结合补体(第20章),吞噬细胞可以结合以下物质:
• 被补体成分包裹的病原体
• 抗原-抗体和补体复合物(免疫复合物)
• 死亡细胞
免疫球蛋白受体
吞噬细胞通过其Fc受体识别免疫球蛋白G(IgG)。IgG能刺激吞噬作用,因此起到调理蛋白的作用。
吞噬细胞的作用
巨噬细胞和中性粒细胞具有不同的作用(见Table21.1)。这两种细胞都通过吞噬作用、释放有毒分子和酶来杀死病原体。然而,只有中性粒细胞才能产生中性粒细胞胞外诱捕网(NETs)。中性粒细胞在遇到病原体后不能存活很长时间,它的主要功能是杀伤。在它们延长寿命的过程中,巨噬细胞与先天免疫系统和获得性免疫系统的通信起着至关重要的作用。
吞噬作用
吞噬作用是通过与上述受体之一结合而触发的代谢活性过程。被补体或IgG调理的病原体能最有效地激活吞噬作用(Fig.21.5)。吞噬小体是通过摄取颗粒物质形成的,许多病原体已经形成防御机制,以避免被吞噬细胞破坏。

Fig 21.5 吞噬细胞的杀伤力
氧化爆发
吞噬后,三条相互关联的酶通路被激活,产生有毒分子,进一步杀伤病原体(Fig.21.6)。这些酶产生过氧化氢(吞噬细胞烟酰胺腺嘌呤二核苷酸磷酸[NADPH]氧化酶)、次氯酸(漂白剂[髓过氧化物酶])和一氧化氮(诱导型一氧化氮合酶[巨噬细胞,非中性粒细胞])。吞噬细胞NADPH氧化酶在慢性肉芽肿病的原发性免疫缺陷中存在缺陷(见Box21.3)
一氧化氮(NO)是一种特殊的分子,因为它除了对病原体有毒性外,还是一种重要的信使。神经元和内皮细胞可产生少量NO,在维持血管张力方面起着神经递质的作用。当诱导型一氧化氮合酶被激活时,巨噬细胞可以产生高浓度的NO。高浓度NO能够降低血管张力和心输出量,并导致感染性休克的低血压(见Box21.1)。证据还表明,NO是一种信使分子,可以促进T细胞的作用,导致慢性炎症。

Fig 21.6 氧化爆发
蛋白水解酶
巨噬细胞溶酶体中含有蛋白水解酶,这些酶在巨噬细胞存活的时间里能够再生。在中性粒细胞中,蛋白水解酶存在于颗粒中,使得细胞具有独特的外观。这些颗粒不能再生,当颗粒用完后,细胞就会死亡。目前细胞中存在的酶主要是蛋白水解酶,它能够在溶酶体的酸性pH中水解细菌。在巨噬细胞中,被水解的肽可以被提呈给T细胞。
蛋白水解酶通常在溶酶体中。丝氨酸蛋白酶抑制剂可以防止从吞噬细胞中渗出的酶破坏组织,例如α1-抗胰蛋白酶 (见Box20.3)。其他物质被释放到吞噬体中,包括防御素和乳铁蛋白。防御素是一种能在细菌上形成通道的低分子多肽。乳铁蛋白与铁结合后使细菌失去这种重要的营养物质。
第三种中性粒细胞特有的杀伤机制是NETs的形成。NETs是中性粒细胞坏死或者凋亡后形成一种特殊的结构,它是中性粒细胞的杀菌利器。当病原体太大或太多无法吞噬时,NETs能进行帮助。一旦NETs被激活,中性粒细胞就会分解自己的细胞膜,排出染色质(DNA和组蛋白的混合物)(Fig.21.7)。染色质解体产生凹陷,物理上捕获病原体。同样,毒素分子和蛋白水解酶也会受到NETs的限制,这样病原体就能被消灭了。这是一种冒险的策略:当DNA存在于细胞外空间时,它将会成为一种潜在的抗原。因此,它在NETs中的存在可能有利于系统性红斑狼疮的发生。

Fig 21.7 中性粒细胞形成NETs以应对无法吞噬的细菌
炎症信号
中性粒细胞和巨噬细胞可产生被称为前列腺素和白三烯的炎症介质。这些内容将在第22章中进行详细讨论。尽管中性粒细胞分泌趋化因子和一氧化氮,但它们的寿命短,无法促进稳定、持久的炎症反应,而短暂的反应通常伴有脓液的形成,这种类型的反应称为化脓性反应。
相比之下,巨噬细胞在刺激慢性炎症方面起着关键作用,主要是通过分泌具有局部和全身效应的可溶性信使。巨噬细胞也是重要的APC,因为它们能处理抗原,分泌细胞因子,并表达高水平的共刺激分子和MHC II 类分子(分别为第16章和第8章)。如果抗原不被清除,炎症就会转为慢性导致肉芽肿的形成。本书将在第23章中更全面地讨论肉芽肿,Fig21.8展示了巨噬细胞和T细胞产生的介质如何促进慢性炎症的发生。

Fig 21.8 巨噬细胞和T细胞产生的介质促进慢性炎症发生的过程
急性期反应
巨噬细胞通过模式识别分子识别病原体后分泌IL-1、IL-6和肿瘤坏死因子(TNF)。这些细胞因子增加补体的产生并辅助适应性免疫系统(第19章)。TNF对新陈代谢有直接影响,也可以增加体内储存的脂肪的分解。
IL-1、IL-6和TNF也可通过下丘脑的受体影响中枢神经系统。发生的反应主要是体温升高,感染引发的免疫反应开始后体温会迅速地上升。体温升高能够抑制病毒和细菌的复制。还会增加代谢率,使食欲下降,这些原因会导致在严重感染时体重下降。巨噬细胞也会分泌细胞因子来激活免疫系统的其他部分。IL-8是一种吸引中性粒细胞到感染部位的趋化因子。这些细胞因子主要激活先天免疫系统,但是通过TLRs刺激的树突状细胞可以分泌IL-12,它在激活适应性免疫系统的邻近T细胞方面发挥作用,提醒适应性免疫系统注意感染的存在。
吞噬细胞缺陷
吞噬细胞的原发性疾病是罕见的,但会引发一些严重的问题,如慢性肉芽肿性疾病。(见 Box21.3),继发性吞噬细胞缺陷更为常见。最重要的是中性粒细胞减少,这通常是药物治疗引起的(见 Box21.1)。吞噬细胞功能受损也可继发于一些其他疾病,如糖尿病和肾功能衰竭,以及在皮质类固醇治疗期间(Fig.21.9)。普通剂量下的皮质类固醇作用于吞噬细胞;较高剂量下则作用于淋巴细胞。因为皮质类固醇能有效地消炎,所以被广泛用于治疗疾病。然而它们也有很多副作用,例如,它们会抑制对感染的免疫力,导致新陈代谢问题和高血压。

Fig 21.9 皮质类固醇对吞噬细胞功能的影响。
先天免疫系统和获得性免疫系统的分子识别
在这里,回顾免疫系统的两个分支识别不同分子的方式是有必要的。适应性免疫系统可以利用MHC分子、T细胞受体和Ig分子识别数百万种可能的抗原,并且它可以区分自身和非自身抗原。然而,适应性免疫系统的细胞不能区分正常的动态平衡环境和“危险”的环境。这意味着,如果适应性免疫系统能够自动启动应答,它就可以与自身多肽反应并启动自身免疫(第28章)。相比之下,先天免疫系统能够识别由组织损伤或感染引起的“危险”信号。先天系统中的模式识别受体(PRRs)只能识别病原体相关的分子模式(PAMPs) 或损害相关的分子模式(DAMPs)。例如通过TLR激活表达它们的细胞,如巨噬细胞被激活后可表达更多的MHC分子和共刺激分子(如CD80),还可分泌细胞因子。共刺激分子的表达以及细胞因子的分泌被称为危险信号,T细胞只有在收到危险信号时才能对抗原产生反应。因此,先天免疫系统可通过释放危险信号的方式向适应性免疫系统发出警报。这构成了外周耐受的一部分(第18章),降低了适应性免疫系统对自身抗原或无害的环境抗原做出反应的风险。
巨噬细胞也依赖于适应性免疫系统,特别是TH1细胞。例如,lgG的产生需要TH1帮助,这种免疫球蛋白在调理细菌供Fc受体识别方面最有效。此外,正如你将在第23章中发现的那样,TH1产生的干扰素γ(IFN-γ)对慢性感染期间支持和维持巨噬细胞具有重要作用。
许多人错误地认为适应性免疫系统独立于先天免疫系统发挥作用,现在我们已经看到情况并非如此。APCs必须首先检测入侵的病原体,然后才能通过共刺激作用激活T细胞。
BOX 21.1中性粒细胞减少性脓毒症致感染性休克
12岁女孩因急性淋巴细胞白血病接受细胞毒性化疗。尽管有证据表明白血病对药物有反应,但她已经变得缺乏中性粒细胞 (中性粒细胞<0.5×10^6mL)。傍晚早些时候,她出现发抖(身体僵硬)和发冷,伴有发热。半小时内发生休克,并出现心动过速和低血压的特征,同时伴有外周温暖现象。医生检查她时,没有发现局部器官受累的迹象,如肺炎,因此诊断为中性粒细胞减少症合并感染性休克。
取患者的血进行培养,培养出大肠杆菌,然后患者开始使用抗生素和补液。在接下来的12个小时里,她的病情逐渐好转(Fig.21.10)。

Fig 21.10 病人的生命体征。蓝色菱形代表脉搏(每分钟跳动),黑条代表血压(毫米汞柱),黄色三角形代表体温
中性粒细胞在细菌感染的早期起着至关重要的作用。当中性粒细胞存在并且功能正常时,它们会将感染限制在入侵部位并产生脓液。这会产生一些体征,如肺炎或脓肿的形成。中性粒细胞减少的患者,中性粒细胞不能定位感染,感染会迅速扩散到血液和其他组织。但免疫系统的其他细胞,特别是巨噬细胞仍然能够正常运作;例如这这位病人能够出现急性期反应,伴有发烧和寒颤。感染性休克是正常的先天感染反应中的一种严重反应。它是一种急性低血压状态,常由细菌脂多糖引起。休克是血管张力下降和心输出量减少的结果,感染性休克在中性粒细胞减少的患者中很常见,其中革兰氏阴性菌引起的病例较多。它也可见于免疫系统正常的患者,他们因大量微生物存在而被感染压垮。例如,在肠道破裂后,数十亿细菌被释放出来,或者是因为个人对高毒力的有机体没有免疫力,就像埃博拉病毒一样。
内毒素的释放通过TLRs激活巨噬细胞触发先天免疫反应,巨噬细胞活化后能够分泌TNF、前列腺素和NO。TNF刺激平滑肌和内皮细胞产生更多NO。高水平的NO是降低血管张力和心输出量的原因,应该记住,正常水平的NO有助于维持血管张力。内皮细胞的激活也可能触发凝血级联反应。
感染性休克通常会引发器官衰竭,特别是当凝血级联反应也被激活时。多器官衰竭不是初次感染的直接后果,而是由先天免疫系统对感染的反应引起的。由于先天性免疫系统过度激活而导致的多器官功能衰竭综合征,有时被称为全身性炎症反应综合征(SIRS)或细胞因子风暴,其死亡率高达70%以上。先天免疫系统的过度激活难以被阻止(Fig.21.11),且已有的对感染性休克的治疗效果不好,所以临床医生特别重视其预防,包括采取减少感染风险的措施,如确保彻底洗手和避免中性粒细胞减少症的发生,以及监测住院患者是否有脓毒症的早期迹象。急性输血反应是发生SIRS的另一个原因(第29章)。毒素休克综合征是由T细胞分泌的细胞因子介导的一种不同的病症。
这个例子说明了对中性粒细胞减少患者感染的早期症状作出迅速反应是多么重要。

Fig 21.11 逆转感染性休克影响的各种尝试
BOX 21.2基于Toll样受体配体的药物
刺激TLRs对免疫系统的许多成分有很强的激活作用。在临床医学中,有两个领域需要增强免疫反应:癌症和疫苗,这将在接下来的章节中进一步讨论。因为癌症和疫苗不是传染病,它们不擅长发出危险信号,并且免疫系统往往不会像我们希望的那样做出反应。未甲基化的胞嘧啶和鸟苷序列(CpG基序)和咪喹莫特这两种TLRs配体可以安全地模拟感染,并已在这些环境中进行了测试。
CpG基序存在于细菌中,而在人类细胞中不存在。它们能有效地刺激表达TLR-9的树突状细胞分泌IL-12,从而促进TH1的反应,并促进随后产生免疫球蛋白G (IgG)和细胞毒性T淋巴细胞(Fig.21.12)。当与现有疫苗联合使用时,CpGs可以改善抗体和T细胞应答。当与常规治疗相结合时,CpGs在一些癌症的临床试验中也被发现是有效的,并且似乎没有副作用。

Fig 21.12 CpGs和咪喹莫特模拟危险信号并增强TH1对抗原的反应
咪喹莫特是一种合成药物,它模仿单链RNA,刺激TLR-7,也可以刺激巨噬细胞和树突状细胞。然后,这些细胞分泌大量的细胞因子,刺激先天免疫系统和获得性免疫系统。咪喹莫特被广泛用于治疗疣感染。像许多慢性病毒感染一样,导致疣的病毒能够在细胞内缓慢复制,而不会产生强烈的危险信号。咪喹莫特涂在疣上是一种非常有效的治疗方法。咪喹莫特可以增强疫苗的效果,并已被用于治疗肿瘤。其优点是可直接应用于某些皮肤肿瘤,疗效显著。
BOX 23.3慢性肉芽肿性疾病
4岁男童,高烧,左侧胸腔积液,胸腔样本检测为脓液,细菌培养:金黄色葡萄球菌。这名儿童有生长迟缓和肛周脓肿的病史。他没有兄弟姐妹,家族史:他的舅舅在十几岁时死于感染。血液检查显示,中性粒细胞明显升高,为23×106mL(正常:3~6×106mL)。硝基蓝四氮唑试验可以用来确定他的中性粒细胞是否能够形成氧化爆发(Fig 21.13)。结果显示患者的中性粒细胞不能形成氧化爆发,这与慢性肉芽肿性疾病(CGD)的诊断一致。CGD是一种影响中性粒细胞功能的原发性免疫缺陷。该疾病的特点是会反复出现可引起中性粒细胞增多的细菌和真菌感染。它是由烟酰胺腺嘌呤二核苷酸磷酸(NADPH)氧化酶或其调节蛋白的基因突变引起的。
CGD通常是X连锁的。虽然可以大量产生的中性粒细胞能够迁移到感染部位,但它们不能产生超氧阴离子自由基,也不能杀死病原体。病原体通常会导致短暂的脓液而形成感染,如果没有被清除,会进一步形成慢性感染典型的肉芽肿,如真菌曲霉菌和葡萄球菌(第23章)。
患有CGD的儿童感染的预防可以通过使用预防性抗生素和抗真菌药物,如今已经尝试了其他方法,如干细胞移植。

Fig 21.13 硝基蓝四氮唑(NBT)试验。NBT是一种淡黄色,但在经历了氧化爆发的细胞中会变成紫色。A,来自正常捐献者的中性粒细胞被刺激,NBT产生黑色。B,慢性肉芽肿患者的中性粒细胞不能改变染料的颜色。未见胞浆染色,可见多叶细胞核。
— THE END —
▉ 往期文章目录
基础免疫学系列
肿瘤免疫学系列
即将开始,敬请期待!
生信入门学习笔记系列
基础实验技术系列
Annexin V/PI染色检测细胞凋亡-OncoLab实验室
仪器操作系列
蔡司LSM800激光共聚焦显微镜操作视频-中西医结合基础研究中心
IN Cell Analyzer2200高内涵细胞成像分析系统操作教程-中西医结合基础研究中心
文献分享系列
年度巨献:神刊CA发布最新癌症数据:全球1000万人死于癌症,中国占比超3成
HLA-I分子加工和递呈抗原功能受损是免疫检查点抑制剂耐药的重要原因
作图投稿选刊系列
GraphPad+AI制作可发表级别的柱状图-OncoLab实验室
PubMed中如何按影响因子筛选检索结果并显示影响因子及分区?
如何使用EndNote软件插入参考文献(附6813种杂志参考文献格式文件)
健康养生系列

长按上方二维码即可关注本号~
本篇文章来源于微信公众号: OncoLab
微信扫一扫打赏
支付宝扫一扫打赏